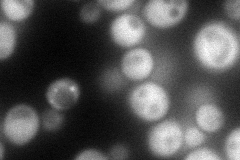
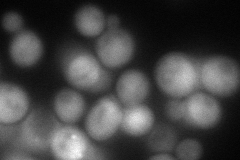
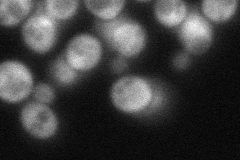
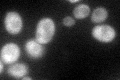

View description
Beta subunit of the translation initiation factor eIF2B, the guanine-nucleotide exchange factor for eIF2; activity subsequently regulated by phosphorylated eIF2; first identified as a negative regulator of GCN4 expression
Localization:
Intensity:
Fold change:
Significance:
-
C’ GFP library in SD

punctate, cytosol78.38 -
N' NOP1pr-GFP in SD
cytosol95.9672 -
N' TEF2pr-mCherry in SD
cytosol,punctate100.875 -
N' NATIVEpr-GFP in SD
cytosol53.2942 -
N' TEF2pr-VC and Cyto-VN in SD

cytosol41.6793 -
C’ GFP library in SD+DTT

punctate, cytosol60.950.77No -
C’ GFP library in SD+H2O2

cytosolN/AN/ANo -
C’ GFP library in Starvation Media
cytosolN/AN/AYes -
C’ GFP library on the background of Pup2-DaMP

punctate, cytosol -
C’ GFP library on the background of CCT mutant

punctate, cytosol70.0290.893322No
